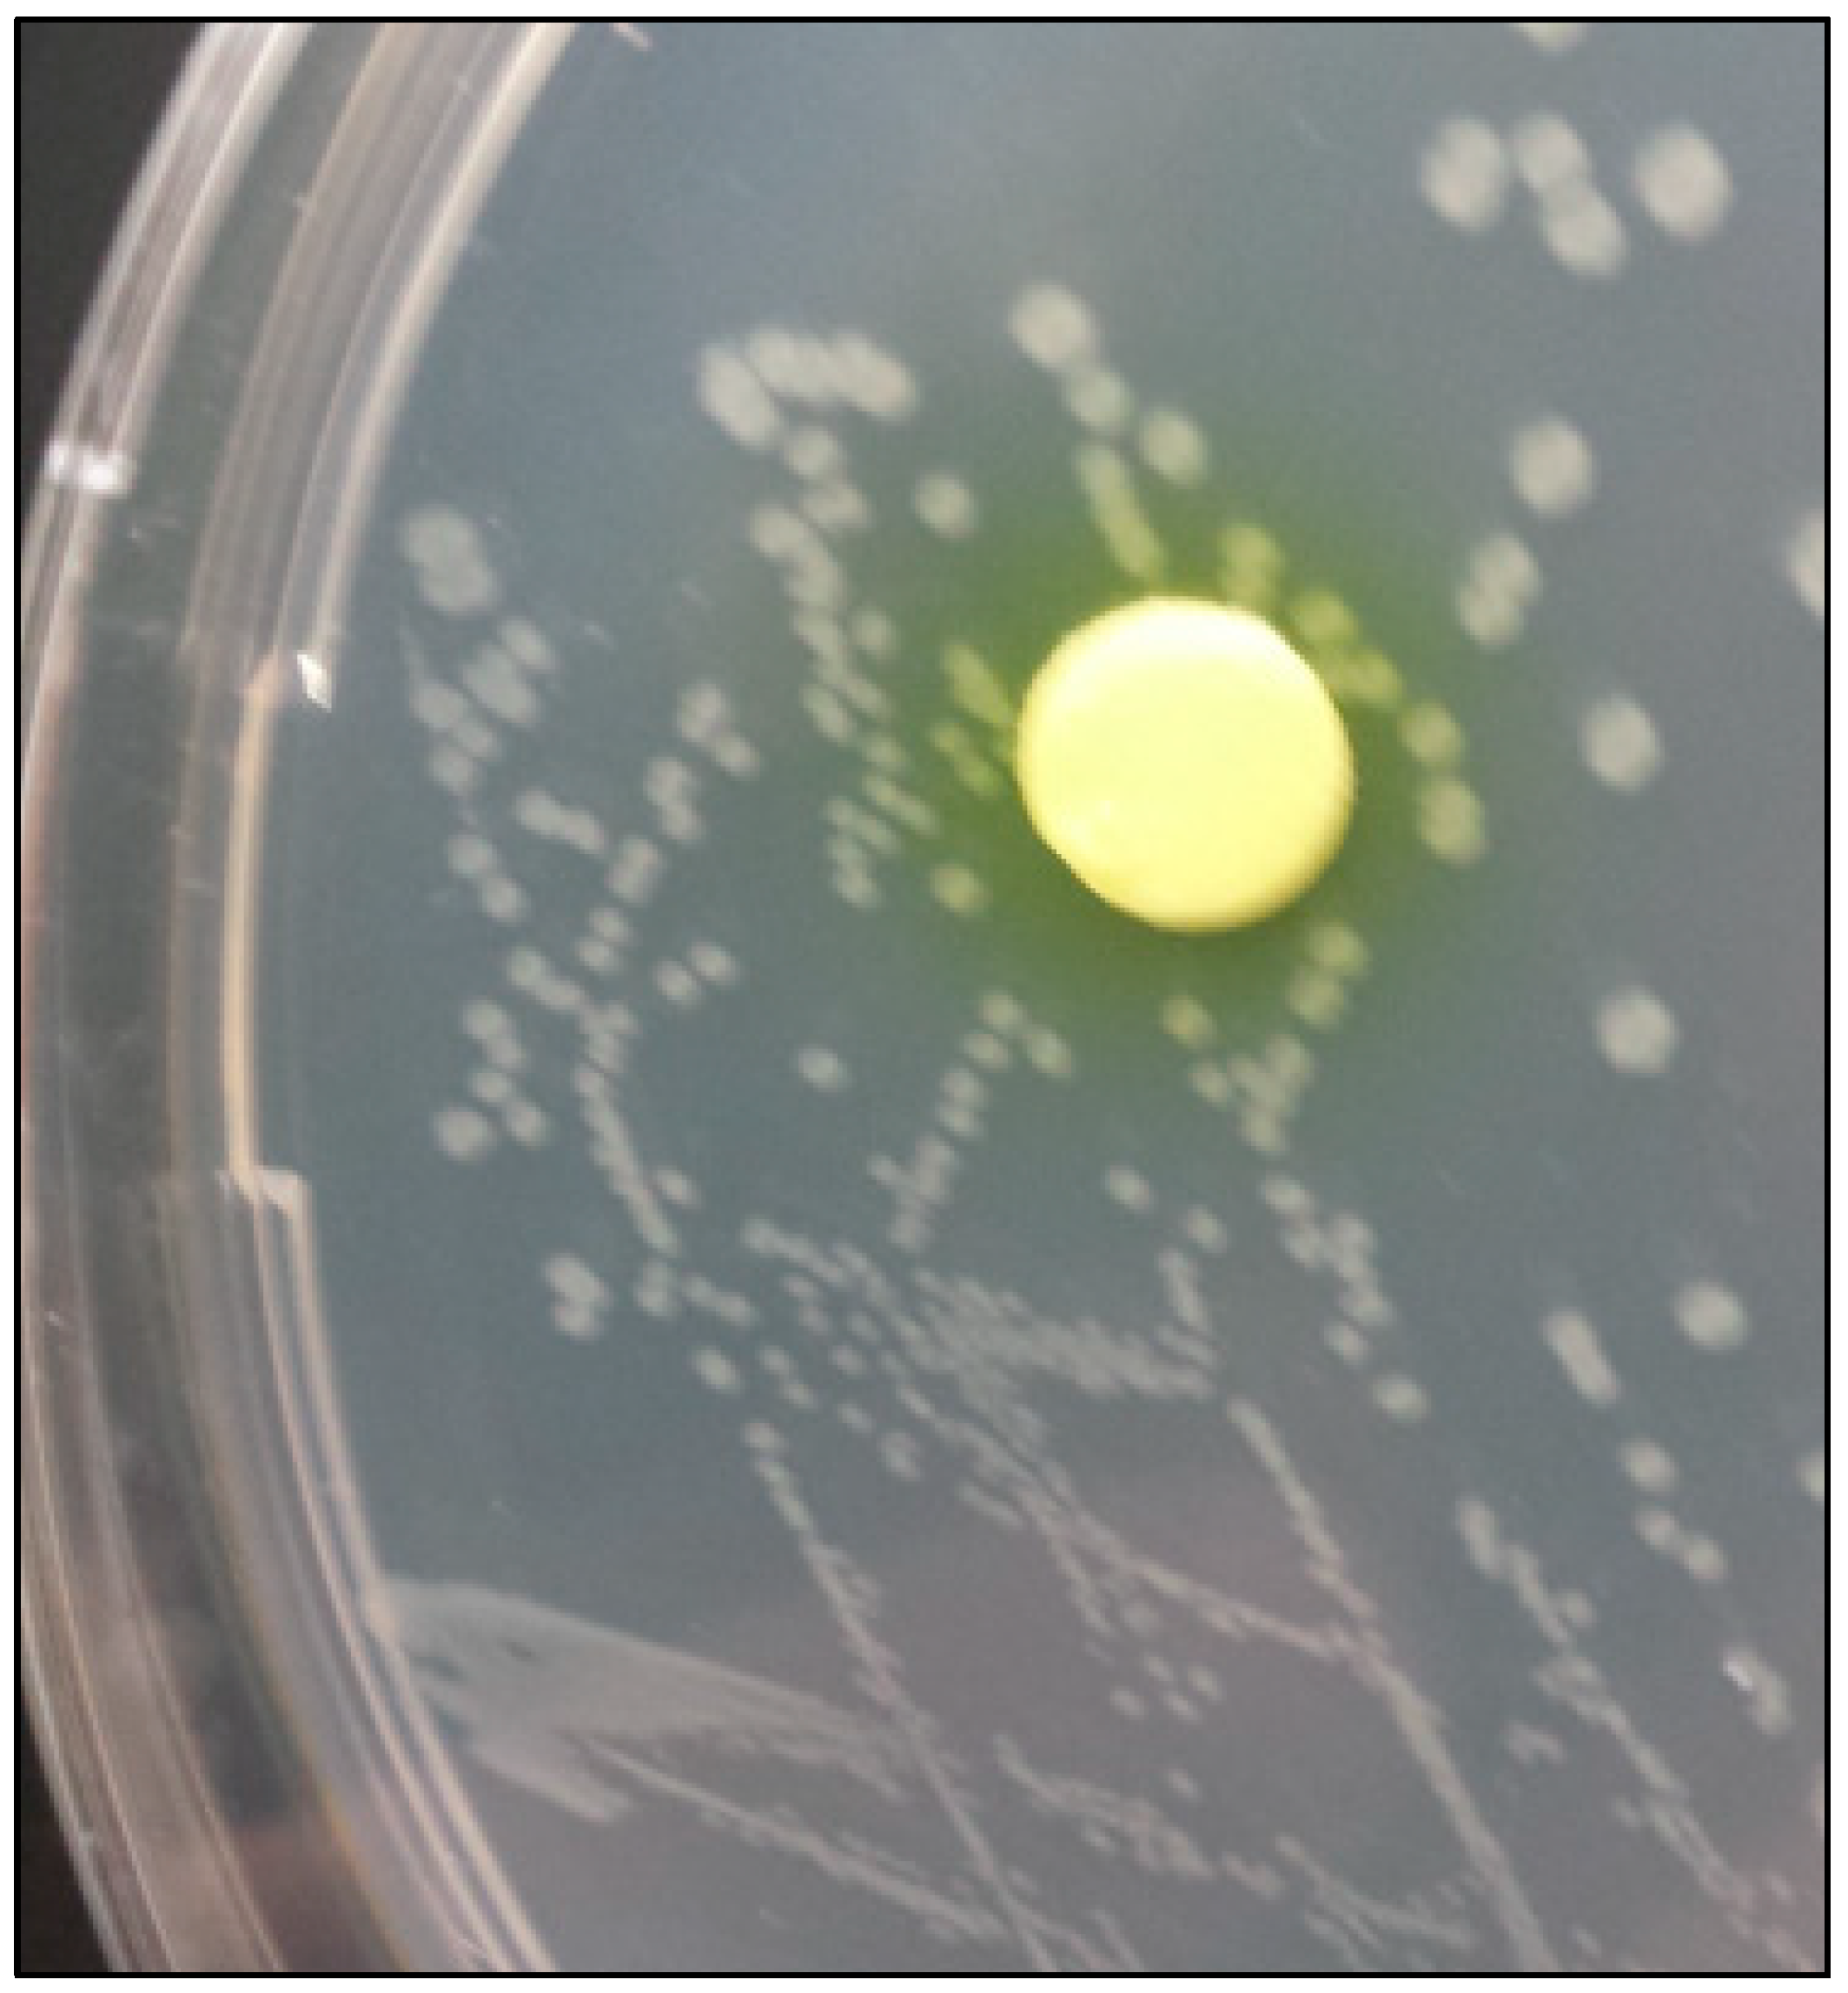
Preprints 70117 g001

1. Introduction
The natural widespread occurrence of heavy metals in all the world’s ecosystems (Martin, 2012) is mainly due to the pedogenetic processes leading to the weathering of soil parent materials (Medfu et al., 2020). Thanks to such a process, living organisms are supplied with such elements, which are essential for their normal functioning (Prasad et al., 1999). Industrialized societies are responsible for increasing the environmental concentration of heavy metals, largely beyond their safe threshold levels, through wastes produced both by industrial and agricultural processes and household activities (Dumontet et al., 2001). The high concentration of heavy metals found in the environment is responsible for severe toxic effects on exposed plants, animals, and humans. The detrimental effect of heavy metals is mainly due to their capability of combining with biomolecules, especially proteins, acting as potent enzyme inhibitors, hampering that way biochemical processes, and compromising the stability of genetic material and cell membrane integrity (Poli et al., 2009).
Heavy metals contamination is listed among the most alarming threat to the environment and human health (Mishra et al., 2019) and heavy metals have been classified as priority pollutants by most of the world’s environmental protection agencies (Srivastava and Goyal, 2010; Tchounwou et al., 2012; Mohod et al., 2013; Li et al., 2014; Aprile and De Bellis, 2020).
The detrimental effects of heavy metals in the natural environment span from a reduction of biodiversity (Tovar-Sánchez et al., 2018), to toxic effects on marine life through microplastic-borne heavy metals (Brennecke et al., 2016), to impairment of microbial activity in soil (Abdu et al., 2017), to plant toxicity (Nagajyoti et al., 2010) and to various toxicological effects on fishes and animals (Pandey and Madhuri, 2014), including the impairment of their reproductive potential (Verma et al., 2018). An excellent review on the noxious effect of heavy metals on human health is reported by Jaishankar et al. (2014).
Different chemical and biological technologies have been developed to alleviate environmental contamination by heavy metals. Among them, chemical precipitation, coagulation, flocculation, filtration, reverse osmosis, ion exchange, biosorption, aerobic and anaerobic microbial degradation were proposed (Abbas et al., 2018). Focusing on biotechnologies, biosorption received particular attention for its effectiveness in the removal of metals from different environmental matrices and for its cost-effectiveness and eco-friendly nature (Das et al., 2008; Abbas et al., 2014). However, less attention has been paid to the microbial precipitation of heavy metal as a side mechanism of the most general process of microbial induced calcite precipitation (MICP). This process received a great deal of interest from both a theoretical and practical standpoint (Jarwar et al., 2022) and could assist in the endeavour of alleviating heavy metals contamination, by removing metals through their inclusion in carbonate minerals precipitated thanks to the microbial intervention.
The study of heavy metal co-precipitation has been interpreted as the result of various mechanisms, spanning from purely chemical reactions (Crawford et al., 1993; Pérez-Garrido et al., 2007; Sánchez-Pastor et al., 2011; Cruz et al., 2011; Roza-Llera et al., 2021), to a process mediated by heterotrophic and photosynthetic microorganisms (Podda et al., 1995, Bai et al., 2021). Wang et al. (2018) reviewed, from a more practical point of view, the studies aimed at microbial induced carbonate precipitation for the immobilization of heavy metals, in an attempt to suggest an effective way to alleviate such an environmental threat. The critical point of all the studies reviewed by Wang et al. (2018) remains the choice of a suitable microorganism able to induce a massive co-precipitation of carbonate and heavy metals.
The aim of this study was to analyse the feasibility of co-precipitate Cd, Cr, Pb, and Zn with carbonate minerals, thanks to the intervention of the bacteria Vibrio harveyi, from solutions containing CaCl2 and Cd, Pb, Cr, and Zn in form of nitrates. The effectiveness of such an attempt was proved by the substantial reduction of heavy metals in the solutions and the production of different carbonates, as a function of the different metals. The strain of V. harveyi used here shoved the ability to precipitate massive amounts of carbonates in a short time.
2. Materials and Methods
2.1. Isolation of heterotrophic CaCO3-biomineralizing bacteria strain
The bacterial strain of Vibrio harveyi used in this study was isolated from sea sediment collected on the coastline of the city of Pozzuoli (Gulf of Naples, Southern Italy), an area subjected to a severe heavy metal contamination in the recent past (Angeli et al., 2023). Three g of sediment were inoculated in a tube containing Precipitation Broth Medium (PBM) containing 3 g⋅L−1 of nutrient broth (Oxoid, Basingstoke, Hampshire, United Kingdom), 2 g⋅L−1 of NaCl (Oxoid, Basingstoke, Hampshire, United Kingdom ), 36.68 g/L g⋅L−1 of CaCl2⋅2H2O (Sigma-Aldrich, Darmstadt, Germany ), and 20 g⋅L−1 of urea (Bio-Rad Laboratories, Hercules, CA, USA). The broth culture was incubated aerobically at 30 °C in static conditions until the formation of crystals was visible to the naked eye. The supernatant and the sediment were then removed and the tube was washed 3 times with sterile saline solution (0.9% NaCl). Five more ml of saline solution were then added and the crystals adhering to the surfaces of the test tube were detached and fragmented with a sterile spatula. After vortexing for 1 min, a suspension loopful was streaked onto plates of TSA-Ca. The TSA-Ca was composed of Tryptone Soya Agar (Oxoid, Basingstoke, Hampshire, United Kingdom) supplemented with 1 g⋅L−1 of CaCl2⋅2H2O. After incubation at 30 °C for 48 h, bacterial colonies showing the crystal formation were selected and purified on Trypton Soy Agar (Oxoid, Basingstoke, Hampshire, United Kingdom). After incubation, one of the grown colonies was biochemically characterized and molecularly identified.
2.2. Biochemical characterization and molecular identification of bacterial strain
2.2.1. Urease activity
Qualitative urease activity was performed by inoculating the strain into Urea Indole Medium (Bio-Rad Laboratories, Hercules, CA, USA) and incubating at 30 °C for up to 3 days in aerobic conditions. The microorganisms producing the urease enzyme, released ammonium from the hydrolysis of the urea inducing a color change from yellow to red-fuchsia in the medium.
2.2.2. Carbonic Anhydrase Assay
A carbonic anhydrase (CA) assay was performed by using cellulose disks (∅ 5 mm) containing 0.0067 g of p-nitrophenyl-acetate (p-NPA). Briefly, 0.1 g of p-NPA (Sigma-Aldrich, Darmstadt, Germany) was dissolved in 3 ml of absolute ethanol; blank antimicrobial susceptibility disks (Oxoid) were soaked with 20 µl of the p-NPA solution, left to dry at 37 °C.
The CA assay was performed by placing a disk near the colony of the selected bacterial strains grown in TSA at 30 °C for 48 h. The CA-producing bacteria, by inducing the cleavage of p-NPA to p-nitrophenol and acetate, produces the yellowing of the disk and the surrounding area within 5 minutes.
2.2.3. Molecular identification of bacterial strain
The selected strains were identified using PCR amplification and direct Sanger sequencing of the 16S ribosomal RNA gene. DNA was extracted from colonies grown on TSA using Lyses & PCR-GO Kit (Bacteria/Fungi) following the manufacturer’s instructions. PCR amplification was carried out by sequencing the 16S rRNA gene (region V1-V6) using universal primers 63f (5′-CAG GCC TAA CAC ATG CAA GTC-3′) for the forward primer and 1387r (5′-GGG CGG WGT GTA CAA GGC-3′) for the reverse primer (Marchesi et al., 1998). PCRs were performed with the following conditions: initial denaturation at 98 °C for 5 secs, followed by 35 cycles of denaturation at 98 °C for 5 secs, annealing at 55 °C for 5 secs, and extension at 72 °C for 18 secs; final extension at 72 °C for 45 secs.
Sanger sequencing was performed by using a 3130 Genetic Analyzer (Life Technologies o Applied Biosystems, Carlsbad, CA). A sequence similarity search was performed using the BLAST algorithm against the GenBank database (
http://blast.ncbi.nlm.nih.gov/Blast.cgi).
2.3. Heavy metal bio-precipitation
In order to check the heavy metal resistance of the bacterial strain selected for this experiment, colonies of V. harveyi grown on TSA, after incubation at 30 °C for 24 h, were suspended in Nutrient Broth (Oxoid, Basingstoke, Hampshire, United Kingdom), spiked with 100 ppm of the single heavy metal used here. V. harveyi cells were added to the solutions up to reach a McFarland standard of 0.5 and then incubated for 48h at 30°C.
Colonies of V. harveyi grown on TSA, after incubation at 30 °C for 24 h, were suspended in the sterile saline solution until the McFarland turbidity standard no 2 was reached. Then, 20 μL of the cell suspension were inoculated in triplicate test tubes containing 10 mL of liquid medium, made by Nutrient Broth (Oxoid, Basingstoke, Hampshire, United Kingdom) 3 g⋅L−1 , urea (Oxoid, Basingstoke, Hampshire, United Kingdom) 20 g⋅L−1, CaCl2⋅2H2O (Sigma-Aldrich, Darmstadt, Germany) 18.34 g⋅L−1, NaCl (Oxoid, Basingstoke, Hampshire, United Kingdom) 20 g⋅L−1. To these media, 100 ppm of Cd, Pb, Cr, and Zn, in form of NO3- , were singularly added. A treatment containing all the tested heavy metals, at a concentration of 100 ppm of each metal was also made. Treatments containing each one of the heavy metals tested, with no microbial inoculation, were used as a negative control. All the cultures were incubated, aerobically and in a static condition, for 10 days at 25 °C.
After incubation, the broth cultures were centrifuged and the supernatant was collected to determine the concentration of heavy metals. The crystals adhering to the surfaces and the crystals precipitated on the bottom of the test tubes were collected to carry out mineralogical characterization and SEM observations.
2.4. Metal concentrations
Supernatants were filtered through 0.2 µm pore-size acetate filters and then digested with H2O2 under UV radiation. These solutions were analyzed for dissolved Cd2+, Cr2+, Pb2+, and Zn2+ content by voltammetric analysis carried out with a Metrohm 797 VA Computrace equipped with a multimode working Mercury electrode (Anodic stripping voltammetry -ASV with the hanging mercury drop electrode - HMDE). An Ag/AgCl electrode and a Pt electrode were used as reference and auxiliary electrode respectively. For calibration, the standard addition method was applied to limit the matrix effects. All elements were quantified using linear regression; quality control and method’s accuracy were as reported in Chianese et al. (2019).
Pb concentration analyses of calcite crystals were carried out by interaction with hydrogen peroxide to remove organic matter prior to nitric acid digestion of the carbonate. Pb was analyzed using SPECTRO Arcos inductively coupled optical emission spectrometer (ICP-AES). This equipment has a simultaneous optical system Paschen-Runge with 32 detectors CCD and operates at 0.7- 1.7 kW that covers a range of wavelengths comprised between 130 and 777 nm. The nebulizer flow is 0.95 ml/min. The analyses were carried out for Pb only due to the extremely fine dimension of crystals in the other experiments, which prevented the necessary quantity of material from being obtained.
2.5. X-ray diffraction and SEM analysis
Crystal adhering on the surfaces and the crystals precipitated on the bottom of the test tubes were examined through random powder X-ray diffraction (XRD) analysis using a Bruker D8 Advance diffractometer with Cu Kαradiation (λ=1.54060 ̊A) and equipped with a Sol-X detector (Bruker, Biller-ica, MA, USA). The samples were scanned from 2 to 65° 2θ with a step size of 0.02° 2θ and accounting time of 0.5 s per step. In the case of non-purified EPS, the counting time per step was 3secs. Match 3 (Crystal Impact) software was used for XRD interpretation.
Textural features and mineral assemblages were established by scanning electron microscopy using images recorded with secondary and backscattered electrons, and energy dispersive X-ray systems (EDX). Some freshly fractured surfaces of representative samples were air-dried and coated with Au under vacuum conditions at 25 mA. Scanning electron microscopy observations were performed using JEOL JSM-7600F Field Emission scanning electron microscopy (FESEM), (JEOL USA Inc.).
3. Results and Discussion
After 48h of incubation in presence of all the single heavy metals here studied, the V. harveyi cultures reached a McFarland standard turbidity of 2.0, demonstrating the heavy metal tolerance of this bacterium to the maximum heavy metals concentration used here.
The results of the test of urease and carbon anhydrase are showed in
Figure 1.
V. harveyi resulted able to express both urease and carbon anhydrase enzymes.
Table 1 shows the amount of heavy metals left in the solutions along the incubation. The efficiency in heavy metal removal varied according to the different heavy metals studied (Cd > Cr > Pb > Zn). At day 2 of incubation only 2.28% (± 3.5 sd) of all metals remained in solution. Zn was the poorly removed among metals and an increase of its concentration in solution was recorded at day 7 and 10, when it reached a value 2.4 times higher than that recorded at day 2. This phenomenon was also observed for Cr, as the concentration in the solution was 15.5 higher at day 10 compared to day 2. The concentration of Pb in the solution was 1.3 time higher at day 10 compared to day 2, whereas for Cd this value was 0.6.
The apparent contradictory results, showing an increase of some heavy metal concentrations in the solution, have a possible explanation in the known ability of microorganisms to both precipitate and dissolve minerals. As matter of facts, evident marks of calcite crystal partial dissolution were evident in the SEM micrographs, as showed in
Figure 2A,
Figure 3A and
Figure 4C. Our findings seem to be in agreement with those of Jacobson and Wu (2009), who, worked with the heterotrophic bacterial species
Burkholderia fungorum, found that the microbially induced calcite crystals produced were dissolved by both the H
2CO
3 generated by dissolution of atmospheric CO
2 in their reacting media (according to the equation H
2CO
3 + CaCO
3 = Ca
2+ + 2HCO
3-) and H
+ released during NH
4+ bacterial uptake (according to the equation H
+ + CaCO
3 = Ca
2+ + HCO
3-). Considering the presence of urea in our reaction media, as well as the ureolytic activity showed by
V. harveyi, the mechanism proposed by Jacobson and Wu (2009) could have outpaced the precipitation of CaCO
3 in the short run. It is interesting to note that this phenomenon occurs in different kinetics as function of the different heavy metals used here. Similarly, Perito and Mastromei (2011) observed that formation of calcite crystals, in presence of gypsum and
Desulfovibrio spp., occurs by a combination of dissolution–precipitation and diffusion processes based on gypsum dissolution and subsequent calcite formation.
In addition, the coupled dissolution-crystallization reactions were frequently observed in both surface and subsurface geological environments (Roza-Llera et al., 2021), involving different carbonate minerals, neo-formed bio-mineral included (Ehrlich, 1996; Johnston et al., 2021).
A possible mechanism driving microbially mediated calcite precipitation has been identified in the diffusion of positively charged Ca2+ ions from the solution to the cell surface and their bonding to negatively charged functional groups of extracellular polymeric substances (EPS) (Li et al., 2014). These same EPS appear to be able to promote mineral dissolution (Welch and Vandevivere, 1994) as well. In other words, the microbes-mineral interplay seems to be characterized by an incessantly alternation of mineral precipitation-mineral dissolution-release of ions-mineral precipitation ad so on. The intriguing thing is that such a process can be mediated through the same compounds: EPS for calcite, and organic acids for clay minerals (Hiebert and Bennett, 1992; Fiore et al., 2011).
Two polymorphs of CaCO3 (calcite and vaterite) were precipitated in different proportions in the experiments. Remarkably, the experiments produced calcite when Cd, Cr, and Pb were concerned, whereas in the Zn experiment vaterite was the dominant mineral phase, suggesting that heavy metals co-precipitate with carbonates which incorporate in the crystal structure (i.e., replacing Ca in the crystal lattices) of the new mineral phase. In case of Zn, this precipitation may influence the CaCO3 polymorph selection leading to vaterite stabilization and partial calcite dissolution with consequent release of Zn into the solution.
In the control experiment both the CaCO3 and heavy metals precipitation were not observed. Thus, the halophilic V. harveyi seems to have played a role in the production of calcite and vaterite in our reaction media. V. harveyi is a well-known hyperhalophilic bacteria (Wang et al., 2022; Han et al., 2022) whose ability to precipitate calcite was reported under extreme halophilic conditions. According to our results, this bacterium seems to be able inducing MICP also in non-halophilic media. This characteristic could potentially enhance the use of V. Harvey in bioremediation technologies by widening the environmental conditions in which it could operate.
V. harveyi was found to be able to produce both urease and carbon anhydrase (
Figure 1). These two characteristics have been often associated with microbially mediated calcite precipitation by alkalinization of the medium (Omoregie
et al., 2021; Pan
et al., 2019; Seifan
et al., 2016; Torres-Aravena
et al., 2018).
3.1. Cd mediated co-precipitation
Identification and morphological characterization of CaCO
3 precipitates were based on XRD data (
Figure 2D) and scanning electron microphotographs (
Figure 2A-C). Calcite was the only CaCO
3 polymorph resulted from the Cd spiked solutions. The majority of calcite crystals exhibited typical rhombohedral morphology, whereas only some of them were prismatic. Crystal dissolution marks, such as irregularly dissolved crystal faces and edges that obliterate the external morphology, are frequently observed (
Figure 2A). Pérez-Garrido
et al., (2007) established that a Cd critical concentration exists that affects calcite dissolution regime at higher impurity concentrations. Cd content estimated by SEM-EDX varies from 0.04 to 1.08 % wt. The adsorption of Cd on calcite crystal faces is a Cd removal secondary process regarding the low Cd concentration on the surface. This assumption can be extended to the other heavy metals (i.e., Cr, Pb and Zn) tested in this study.
3.2. Cr mediated co-precipitation
Chromium-bearing carbonate crystals exhibit a more diverse variety of crystal morphologies than those showed by crystal formed in the Cd-spiked solutions (
Figure 3), as rhombohedral and globular shaped crystals were found. Deep alteration marks were largely visible on the edges and faces of rhombohedral crystals. Complex aggregates of globular crystals grow on the dissolved faces commonly forming complex aggregate suggesting that globular calcite grows at expenses of dissolved rhombohedral calcite. Sánchez-Pastor
et al., (2011) reported an inverse morphological growth pathway in presence of Cr (VI) where calcite spheres dissolved at expense of rhombohedral crystals. Another significant difference in relation to the present study is the stabilization of vaterite at a high concentration of Cr (VI) (Cruz
et al., 2011). The Cr content measured by EDX varies greatly along crystal surfaces (0.21-3.25 % wt). Halite and calcium fluoride were also detected by the XRD analysis (
Figure 3D).
3.3. Pb mediated co-precipitation
Lead-bearing carbonates consist basically of spherical aggregates of rhombohedral calcite crystals (
Figure 4), often coalescing and forming more complex groups. SEM microphotographs reveal irregular dissolution features on rhombohedral crystal faces and edges. The Pb content of such crystals, analyzed by SEM-EDX, varies greatly (0.11-1.53 % wt). Digestion analyses of calcite crystals revealed Pb concentration values of up to 41 ± 1 ppm. This concentration explains the slightly shifting of the reflections to higher d-spacing values in contrast to other heavy metal-bearing calcite diffractograms (
Figure 4D). In contrast to other inorganic mechanisms of Pb interaction with calcite (Roza-Llera
et al., 2021),
V. harveyi metabolism induces Pb-bearing calcite without the presence of secondary lead carbonates (i.e., cerussite and hydrocerussite). In parallel to Cd experiments reported before, dissolution features are observed on the edges of Pb-bearing calcites (
Figure 4C). A threshold of Pb concentration in bio-induced calcites can be established based on these experiments (i.e., ± 40 ppm). In contrast to Cr-bearing cultures, no crystal morphological changes were identified for Cd and Pb.
3.4. Zn mediated co-precipitation
Zn differed from the other heavy metals experiments (i.e., Cd, Cr and Pb) in CaCO
3 polymorph dominant phase (
Figure 5). Up to 80% of the sample consists of vaterite, being calcite residual. To the best of our knowledge, this is the first work that biogenic vaterite is stabilize in a Zn doped medium in the presence of the gram-negative bacteria
Vibrio haveyi. Precipitation of biogenic vaterite was stabilized before by microbial culture of gram-positive bacteria
Bacillus subtilis in the presence of Cd, Ni and Cu (Liu and Lian, 2019). Vaterite exhibits a typical globular crystal morphology, those micrometer crystalline aggregates other are embedded in the bacterial-formed biofilms (
Figure 5 C). The Zn content of vaterite surfaces varies in the same line as in the case of Pb (0.08-1.52 % wt).
In our solutions containing V. harveyi and Cr, the co-precipitation with calcium carbonate produced calcite and not vaterite. These findings are not in agreement with those of Sánchez-Pastor et al., (2011) and Cruz et al., (2011), who reported, based on abiotic experiments, that Cr, co-precipitating with calcium carbonate, was incorporated into vaterite crystal lattice as anionic group (i.e., tetrahedral chromate) substituting triangular carbonate groups (Sanchez-Pastor et al., 2011). Whereas, in our microbial cultures, it seems that Cr was incorporated into calcite crystal structure by replacing Ca ions, as it was in Cd and Pb experiments. In other words, Cr, Cd, and Pb co-precipitate with calcite (i.e., chemical species that directly come from aqueous solution incorporated into carbonate structure). These divalent metals (Cr, Cd, and Pb) are rapidly removed from the solution in the initial stages of co-precipitation followed by a much lower uptake that comes along with crystal dissolution mechanisms. Pérez-Garrido et al., (2007) observed that long-term uptake of divalent heavy metals (i.e., Cd) seems to occur through a dissolution-crystallization mechanism and, to a much lesser extent, through metal adsorption to calcite surface. The results of dissolution-crystallization precipitation process are reflected in the inner zonation of carbonate crystals, where the inner part is chromium-rich (Sánchez-Pastor et al., 2010). On the other hand, Zn has the same effect as the chromate anionic group by stabilizing vaterite over calcite (Cruz et al., 2011). No other heavy metal-bearing carbonate phases such as hydrocerussite or cerussite have been precipitated by V. harveryi in contrast to other abiotic Pb-bearing carbonate experiments (Roza-Llera et al., 2021).
The microanalyses, carried out on calcite containing Pb, demonstrated that calcite incorporated Pb during its crystal growth, leading to hypothesizing the same process for Cd and Cr, and for Zn in the case of vaterite. The precipitation of biogenic metastable vaterite favored by the substitution of Ca by Zn by Vibrio haveryi is, to the best of our knowledge, the first report of a biogenic vaterite in the presence of Zn. Previously, Liu & Lian (2019) precipitate biogenic vaterite doped with Cd, Ni and Cu in the presence of Bacillus subtilis. Furthermore, these observations are in agreement with those of Navrotsky (2004) and Radha et al., (2010), who argued that certain impurities could play a role in the inversion of the energetic stability between the CaCO3 polymorphs.
4. Conclusions
Results show the ability of V. harveyi to co-precipitate calcium carbonates together with Cd, Cr, Pb, and Zn contributing to the immobilization of these metals. Calcite was produced from solutions containing Cd, Cr, and Pb, whereas vaterite was the dominant mineral phase precipitated from the Zn-spiked solutions. Vaterite globular aggregates did not exhibit dissolution features on their surface, like calcite crystals, in which Cd, Cr, and Pb were included, despite calcite is known as the most stable CaCO3 polymorph and vaterite as the most soluble one. All this implies an inversion of the energetic stability between CaCO3 polymorphs produced in presence of different heavy metals.
These results are interesting both from a theoretical and practical standpoint. The different carbonate minerals, formed in presence of different heavy metals, underline the feasibility of bioremediation of natural systems polluted with heavy metals, by allowing them to be included in carbonate minerals. The process appears to be rather effective and fast, as a mean of 97.2% of the 4 heavy metals studied here were included in carbonate minerals after 2 days of incubation, thanks to the activity of V. harveyi. This biotechnology should be based on a microorganism easy to be isolated and cultivated and able to precipitate conspicuous amounts of carbonate minerals in a short run. Being the kinetic of co-precipitation of calcium carbonates and heavy metals rather fast, the process of bio-remediation should be as short as possible in order to avoid that mechanisms of microbial dissolution of carbonate crystals could interfere with mineral precipitation.
Acknowledgments
The authors are indebted to Dr. Gaetano Ricchezza for his technical support. MESM and PB acknowledge the support of the Research group UCM-910404.
References
- Abbas, S.H.; Ismail, I.M.; Mostafa, T.M.; Sulaymon, A.H. Biosorption of heavy metals: a review. J Chem Sci Technol 2014, 3, 74–102. [Google Scholar]
- Abdu, N.; Abdullahi, A.A.; Abdulkadir, A. Heavy metals and soil microbes. Environ. Chem. Lett. 2017, 15, 65–84. [Google Scholar] [CrossRef]
- Aprile, A.; De Bellis, L. Editorial for the special issue “Heavy metals accumulation, toxicity, and detoxification in plants”. Int. J. Mol. Sci. 2020, 21, 4103. [Google Scholar] [CrossRef]
- Angeles, I.B.; Romero-Martínez, M.L.; Cavaliere, M.; Varrella, S.; Francescangeli, F.; Piredda, R.; Frontalini, F. Encapsulated in sediments: eDNA deciphers the ecosystem history of one of the most polluted European marine sites. Environ. Int. 2023, 172, 107738. [Google Scholar] [CrossRef] [PubMed]
- Bai, H.; Liu, D.; Zheng, W.; Ma, L.; Yang, S.; Cao, J.; Mehta, N. Microbially-induced calcium carbonate precipitation by a halophilic ureolytic bacterium and its potential for remediation of heavy metal-contaminated saline environments. Int. Biodeterior. Biodegrad. 2021, 165, 105311. [Google Scholar] [CrossRef]
- Brennecke, D.; Duarte, B.; Paiva, F.; Caçador, I.; Canning-Clode, J. Microplastics as vectors for heavy metal contamination from the marine environment. Estuar. Coast. Shelf Sci. 2016, 178, 189–195. [Google Scholar] [CrossRef]
- Chianese, E.; Tirimberio, G.; Riccio, A. PM2.5 and PM10 in the urban area of Naples: chemical composition, chemical properties and influence of air masses origin. J. Atmos. Chem. 2019, 76, 151–169. [Google Scholar] [CrossRef]
- Crawford, R.J.; Harding, I.H.; Mainwaring, D.E. Adsorption and coprecipitation of multiple heavy metal ions onto the hydrated oxides of iron and chromium. Langmuir 1993, 9, 3057–3062. [Google Scholar] [CrossRef]
- Cruz, J.A.; Sánchez-Pastor, N.; Gigler, A.M.; Fernández-Díaz, L. Vaterite stability in the presence of chromate. Spectrosc. Lett. 2011, 44, 495–499. [Google Scholar] [CrossRef]
- Das, N.; Vimala, R.; Karthika, P. Biosorption of heavy metals–an overview. Indian J. Biotechnol. 2008, 7, 159–169. [Google Scholar]
- Dumontet, S.; Dinel, H.; Schnitzer, M.; Pare, T.; Scopa, A. Composting organic residues: Trace metals and microbial pathogens. Can. J. Soil Sci. 2001, 81, 357–367. [Google Scholar] [CrossRef]
- Ehrlich, H.L. How microbes influence mineral growth and dissolution. Chem. Geol. 1996, 132, 5–9. [Google Scholar] [CrossRef]
- Fiore, S.; Dumontet, S.; Huertas, F.J.; Pasquale, V. Bacteria-induced crystallization of kaolinite. Appl. Clay Sci. 2011, 53, 566–571. [Google Scholar] [CrossRef]
- Han, Z.; Qi, P.; Zhao, Y.; Guo, N.; Yan, H.; Tucker, M.E.; Zhao, H. High Mg/Ca molar ratios promote protodolomite precipitation induced by the extreme halophilic bacterium Vibrio harveyi QPL2. Front. Microbiol. 2022, 13. [Google Scholar] [CrossRef]
- Hiebert, F.K.; Bennett, P.C. Microbial control of silicate weathering in organic-rich groundwater. Science 1992, 258, 278–281. [Google Scholar] [CrossRef]
- Jacob, J.M.; Karthik, C.; Saratale, R.G.; Kumar, S.S.; Prabakar, D.; Kadirvelu, K.; Pugazhendhi, A. Biological approaches to tackle heavy metal pollution: a survey of the literature. J. Environ. Manag. 2018, 217, 56–70. [Google Scholar] [CrossRef]
- Jaishankar, M.; Tseten, T.; Anbalagan, N.; Mathew, B.B.; Beeregowda, K.N. Toxicity, mechanism, and health effects of some heavy metals. Interdiscip. Toxicol. 2014, 7, 60. [Google Scholar] [CrossRef] [PubMed]
- Jacobson, A.D.; Wu, L. Microbial dissolution of calcite at T= 28° C and ambient pCO2. Geochim. Et Cosmochim. Acta 2009, 73, 2314–2331. [Google Scholar] [CrossRef]
- Jarwar, M.A.; Dumontet, S.; Pasquale, V.; Chen, C. Microbial Induced Carbonate Precipitation: Environments, Applications, and Mechanisms. Geomicrobiol. J. 2022, 39, 833–851. [Google Scholar] [CrossRef]
- Johnston, V.E.; Martín-Pérez, A.; Skok, S.; Mulec, J. Microbially-mediated carbonate dissolution and precipitation; towards a protocol for ex-situ, cave-analog cultivation experiments. Int. J. Speleol. 2021, 50, 3. [Google Scholar] [CrossRef]
- Li, Z.; Ma, Z.; van der Kuijp, T.J.; Yuan, Z.; Huang, L. A review of soil heavy metal pollution from mines in China: pollution and health risk assessment. Sci. Total Environ. 2014, 468, 843–853. [Google Scholar] [CrossRef]
- Liu, R.; Lian, B. Non-competitive and competitive adsorption of Cd2+, Ni2+, and Cu2+ by biogenic vaterite. Sci. Total Environ. 2019, 659, 122–130. [Google Scholar] [CrossRef]
- Martin, M. H. Biological monitoring of heavy metal pollution: land and air. Springer Science & Business Media.
- Medfu Tarekegn, M.; Zewdu Salilih, F.; Ishetu, A.I. Microbes are used as a tool for the bioremediation of heavy metals from the environment. Cogent Food Agric. 2020, 6, 1783174. [Google Scholar] [CrossRef]
- Mishra, S.; Bharagava, R.N.; More, N.; Yadav, A.; Zainith, S.; Mani, S.; Chowdhary, P. Heavy metal contamination: an alarming threat to the environment and human health. Environmental biotechnology: For sustainable future 2019, 103-125.
- Mohod, C.V.; Dhote, J. Review of heavy metals in drinking water and their effect on human health. Int. J. Innov. Res. Sci. Eng. Technol. 2013, 2, 2992–2996. [Google Scholar]
- Nagajyoti, P.C.; Lee, K.D.; Sreekanth, T.V.M. Heavy metals, occurrence and toxicity for plants: a review. Environ. Chem. Lett. 2010, 8, 199–216. [Google Scholar] [CrossRef]
- Navrotsky, A. Energetic clues to pathways to biomineralization: Precursors, clusters, and nanoparticles. Proc. Natl. Acad. Sci. 2004, 101, 12096–12101. [Google Scholar] [CrossRef] [PubMed]
- Omoregie, A.I.; Palombo, E.A.; Nissom, P.M. Bioprecipitation of calcium carbonate mediated by ureolysis: A review. Environ. Eng. Res. 2021, 26. [Google Scholar] [CrossRef]
- Pan, L.; Li, Q.; Zhou, Y.; Song, N.; Yu, L.; Wang, X.; …; Huo, J. Effects of different calcium sources on the mineralization and sand curing of CaCO 3 by carbonic anhydrase-producing bacteria. RSC Adv. 2019, 9, 40827–40834. [Google Scholar] [CrossRef] [PubMed]
- Pandey, G.; Madhuri, S. Heavy metals causing toxicity in animals and fishes. Res. J. Anim. Vet. Fish. Sci. 2014, 2, 17–23. [Google Scholar]
- Pérez-Garrido, C.; Fernández-Díaz, L.; Pina, C.M.; Prieto, M. In situ AFM observations of the interaction between calcite surfaces and Cd-bearing aqueous solutions. Surf. Sci. 2007, 601, 5499–5509. [Google Scholar] [CrossRef]
- Perito, B.; Mastromei, G. Molecular basis of bacterial calcium carbonate precipitation. Mol. Biominer. : Aquat. Org. Form. Extraordinary Mater. 2011, 113-139.
- Podda, F.; Zuddas, P.; Minacci, A.; Pepi, M.; Baldi, F. Heavy metal coprecipitation with hydrozincite [Zn5 (CO3) 2 (OH) 6] from mine waters caused by photosynthetic microorganisms. Appl. Environ. Microbiol. 2000, 66, 5092–5098. [Google Scholar] [CrossRef]
- Poli, A.; Salerno, A.; Laezza, G.; Di Donato, P.; Dumontet, S.; Nicolaus, B. Heavy metal resistance of some thermophiles: potential use of α-amylase from Anoxybacillus amylolyticus as a microbial enzymatic bioassay. Res. Microbiol. 2009, 160, 99–106. [Google Scholar] [CrossRef]
- Prasad MN, V.; Hagemeyer, J.; Rengel, Z. Heavy metals as essential nutrients. Heavy metal stress in plants: from molecules to ecosystems 1999, 231-251.
- Roza-Llera, A.; Jiménez, A.; Fernández-Díaz, L. Removal of Pb from wáter: The effectiveness of gypsum and calcite mixtures. Minerals 2021, 11, 66. [Google Scholar] [CrossRef]
- Radha, A.V.; Forbes, T.Z.; Killian, C.E.; Gilbert PU, P.A.; Navrotsky, A. Transformation and crystallization energetics of synthetic and biogenic amorphous calcium carbonate. Proc. Natl. Acad. Sci. USA 2010, 107, 16438–16443. [Google Scholar] [CrossRef]
- Sánchez-Pastor, N.; Cruz, J.A.; Gigler, A.M.; Park, S.; Jordan, G.; Schmal, W.; Fernández-Díaz, L. Microprobe and Raman investigation of the zoning in synthetic (CO3, CrO4) crystals. Macla. 2010, 13, 197–198. [Google Scholar]
- Sánchez-Pastor, N.; Gigler, A.M.; Cruz, J.A.; Park, S.H.; Jordan, G.; Fernández-Díaz, L. Growth of calcium carboante in the presence of Cr (VI). Crystal Growth & Design. 2011, 11, 3081-3089.
- Seifan, M.; Samani, A.K.; Berenjian, A. Induced calcium carbonate precipitation using Bacillus species. Appl. Microbiol. Biotechnol. 2016, 100, 9895–9906. [Google Scholar] [CrossRef] [PubMed]
- Srivastava, S.; Goyal, P. Novel biomaterials: decontamination of toxic metals from wastewater. Springer Science & Business Media.
- Tchounwou, P.B.; Yedjou, C.G.; Patlolla, A.K.; Sutton, D.J. Heavy metal toxicity and the environment. Molecular clinical and environmental toxicology: volume 3: environmental toxicology, 2012, 133-164.
- Torres-Aravena Á, E.; Duarte-Nass, C.; Azócar, L.; Mella-Herrera, R.; Rivas, M.; Jeison, D. Can microbially induced calcite precipitation (MICP) through a ureolytic pathway be successfully applied for removing heavy metals from wastewater? Crystals, 8, 438.
- Tovar-Sánchez, E.; Hernández-Plata, I.; Martinez, M.S.; Valencia-Cuevas, L.; Galante, P.M. Heavy metal pollution as a biodiversity threat. Heavy Metals 2018, 383. [Google Scholar]
- Verma, R.; Vijayalakshmy, K.; Chaudhiry, V. Detrimental impacts of heavy metals on animal reproduction: A review. J. Entomol. Zoo. Stud 2018, 6, 27–30. [Google Scholar]
- Wang, M.; Wu, S.; Yang, Y.; Chen, F. Microbial induced carbonate precipitation and its application for immobilization of heavy metals: a review. Res. Environ. Sci. 2018, 31, 206–214. [Google Scholar]
- Wang, J.; Zhao, Y.; Li, D.; Qi, P.; Gao, X.; Guo, N. ..; Han, Z. Extreme halophilic bacteria promote the surface dolomitization of calcite crystals in solutions with various magnesium concentrations. Chem. Geol. 2022, 606, 120998. [Google Scholar] [CrossRef]
- Welch, S.A.; Vandevivere, P. Effect of microbial and other naturally occurring polymers on mineral dissolution. Geomicrobiol. J. 1994, 12, 227–238. [Google Scholar] [CrossRef]
|
Disclaimer/Publisher’s Note: The statements, opinions and data contained in all publications are solely those of the individual author(s) and contributor(s) and not of MDPI and/or the editor(s). MDPI and/or the editor(s) disclaim responsibility for any injury to people or property resulting from any ideas, methods, instructions or products referred to in the content. |
© 2023 by the authors. Licensee MDPI, Basel, Switzerland. This article is an open access article distributed under the terms and conditions of the Creative Commons Attribution (CC BY) license (http://creativecommons.org/licenses/by/4.0/).